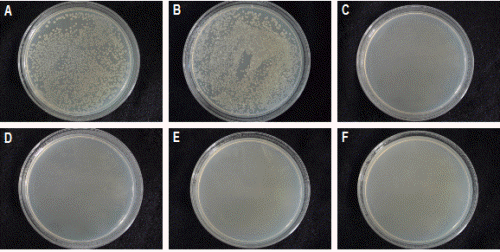
http://static.apub.kr/journalsite/sites/kshs/2014-032-01/N0130320109/images/PICDF28.gif

서 언
절화용 장미는 잎이 많고 넓기 때문에 재배기간 중 수분 요구도가 매우 높은 작물이며(Kim and Lieth, 2012), 수확 후 장미의 절화수명을 결정 짓는 주 요인은 보존용액 내 박테리아 축적에 의한 도관막힘으로 알려져 있다(Hoogerwerf et al., 1989). 도관막힘은 보존용액 내 107-1011CFU・L-1의 박테리아가 축적될 경우 일어나며 수분흡수가 억제되어 절화수명이 단축되게 된다(van Doorn et al., 1989). 박테리아 축적을 억제하여 절화수명을 연장시키는 방법으로 free chlorine(NaOCl, DICA), 8-hydroxyquinoline citrate(HQC), 8-hydroxyquinoline sulfate(HQS), physan 20TM, benzalkonium chloride, aluminium sulphate, silver nitrate와 같은 살균제들이 사용되어 왔다. 하지만 처리농도에 따라서는 줄기 갈변과 잎의 위조 및 탈리를 야기하는 등 식물체에 오히려 독성으로 작용하며(Knee, 2000; van Doorn et al., 1990), 폐기과정에서 환경오염을 유발하고(Florack et al., 1996), 8-HQS의 경우 인체에 유해하여 상업적으로 사용이 제한되기도 한다(Gebhart and Kappauf, 1980). 따라서 사용 후 환경오염을 유발하지 않는 친환경적이면서도 인체에 유해하지 않고 가격이 저렴한 대체살균물질이 요구되고 있다(Florack et al., 1996).
강한 산화제이며 살균제로 알려진 chlorine dioxide(ClO2, 67.46g・mol-1)는 염소계인 유리염소(free chlorine)와 달리 산소계로서 산화력이 높고(Benarde et al., 1965), 암모니아나 질소구성물질과 반응하지 않는 친환경적인 물질로 알려져 있다(Karabulut et al., 2009). 미국, 중국 그리고 EU에서는 ClO2를 식수나 신선 청과물의 살균 및 세척에 사용하고 있으며(Aieta and Brg, 1986; Chen and Zhu, 2011), 미국 식약청(US FDA), 중국 그리고 EU에서는 과일과 채소의 표면소독용으로 허용되어 있다(Chen and Zhu, 2011; Macnish et al., 2008). 우리나라에서도 2010년 8월 농림수산식품부가 ClO2를 유기적 취급물질로 허용하여 식품의 표면세척 소독용으로 이용되고 있다.
절화장미에서 수돗물에 ClO2 5μL・L-1를 처리하여 보존용액 내 박테리아 축적을 억제하여 절화수명을 연장시켰다는 보고가 있으며(Koermer and Wldman, 2002), Alstroemeria ‘Senna’, Antirrhinum ‘Potomic Pink’, Gerbera ‘Lorca’, Gypsophila ‘Perfecta’, Rosa ‘Charlotte’ 등 다양한 절화류에서 ClO2 2-10 μL・L-1가 절화수명을 연장시켰다고 알려져 있다(Macnish et al., 2008). 이때 ClO2의 항균력은 기존 살균제인 aluminum sulfate, DICA, physan 20TM, sodium hypochlorite보다 효과적이며, 8-HQS와는 유사하였다(Macnish et al., 2008). 따라서 본 연구는 국산장미에 대한 ClO2의 절화보존 살균제로서의 이용 가능성을 확인하고 처리 시기에 따른 적정 농도를 알아보고자 수행되었다.
재료 및 방법
식물재료 및 ClO2 처리
2013년 1월 18일 오전 9시 고양시 소재 화훼단지 내 생산농가에서 양액재배로 생산된 스탠다드 절화장미 ‘Beast’ 품종을 상업적 수확단계(Kumar et al., 2008)에 수확하여 1시간 물올림한 후, 암・건식 조건으로 1시간 이내 서울시립대 환경화훼연구실로 수송하였다. 수송된 절화의 줄기를 45cm 길이로 물 속에서 재절단하고 잎은 줄기 기부방향으로 3매엽 3개를 남기고 모두 제거하였다. 줄기 기부로부터 1cm 상부의 직경이 7-9mm에 해당하는 절화를 선별하여 실험재료로 사용하였다. ClO2는 ClO2 발생장치(CA-200, PurgoFarm Inc., Korea)를 이용하여 조제하여 사용하였다. 실험은 보존용액처리와 침지처리로 구분하여 실시하였다. 보존용액처리는 수돗물(tap water, TW), 증류수(distilled water, DW), ClO2 2, 4, 6, 8μL・L-1와 기존 살균제와의 상대적인 처리효과를 알아보고자 8-HQS 200μL・L-1(Ichimura et al., 1999)로 하였다. 침지처리는 ClO2 50, 100, 150, 200, 250μL・L-1에 줄기 끝을 60초간 침지한 후 곧바로 증류수에 옮겨 실시하였다. 각 처리별로 400mL의 보존용액 혹은 증류수가 담긴 유리용기에 절화 1주씩 배치하였고 이를 10반복하였다. 실험환경은 기온 18.4°C, 상대습도 51.5%, 광도 3.6µmol・m-2・s-1, 일장 12시간으로 조절하였다.
절화수명
절화수명 조사는 매일 오전 10시에 조사하였고, 절화수명 한계시점은 꽃목이 30° 이상 굽어지거나, 꽃이 만개되지 않으면서 꽃잎이 시들거나 잎이 마르는 때로 정하였다(Lee and Kim, 2001; Macnish et al., 2008). 실험 시작 전 초기 생체중을 측정하여 실험기간 동안 2일 간격으로 생체중의 변화를 초기 생체중에 대한 백분율로 구하였으며, 용액 흡수율 역시 초기 생체중당 흡수량으로 계산하였다(Chamani and Esmaeilpour, 2007).
항균효과
항균효과를 확인하고자 보존용액 내 ClO2의 잔존농도 변화와 세균수를 조사하였다. 이때 ClO2의 잔존농도가 식물체 유무에 영향을 받는지도 알아보고자 각 처리는 보존용액이 담긴 유리용기에 절화가 들어있는지의 유무로 구분하였고, 이산화염소 분석기(Chlorine Dioxide HI 93738 ISM, Hanna instruments Inc., Woonsocket, USA)와 이산화염소 수질 키트(Chlorine Dioxide Insta test, Lamotte instruments Inc., Chestertown, USA)를 이용하여 ClO2의 잔존 농도를 조사하였다. 처리별 세균수 측정을 위해 처리 6일 후 보존용액을 1mL씩 채취하여 nutrient agar 배지(NA, Difco)에 101-106으로 희석평반법을 실시하여 28°C에서 3일간 배양한 후 조사하였다(van Doorn et al., 1989).
통계처리
통계분석용 프로그램인 SAS package(Statistical analysis system, version 9.2, SAS Institute Inc., USA)를 이용하여 ANOVA(Analysis of variance) 분석을 실시하였으며 각 처리간의 유의성은 DMRT(Duncan’s multiple range test) 5% 수준으로 하였다.
결과 및 고찰
절화수명
대조구(TW)에 비해 ClO2 보존용액처리구와 침지처리구 모두 장미의 절화수명 연장효과가 확인되었으며 ClO2 2-8 μL・L-1 농도간 유의적인 차이를 보이지는 않았다(Table 1). 절화품질 역시 절화수명이 가장 높았던 ClO2 4μL・L-1의 보존용액 처리와 ClO2 250μL・L-1 침지처리구에서는 높게 유지되었다. 기존 연구에서 ClO2 침지처리의 경우 10μL・L-1의 저농도에서는처리효과가 없는 것으로 보고되었으며(Macnish et al., 2008), 본 실험에서는 ClO2 50-250μL・L-1 범위의 고농도로 처리한 결과 절화수명 연장효과가 확인되었다(Table 1). 한편, Ichimura et al.(1999)이 효과적이라고 보고하였던 8-HQS 200μL・L-1 보존용액 처리는 처리 8일부터 줄기갈변현상이 나타나기 시작하였다. 이것은 유리염소(free chlorine)인 DICA와 8-HQC 등의 살균제들도 고농도 처리 시 Alstroemeria aurantiaca ‘Mona Lisa’, Rosa hybrida ‘Sonia’, Tulipa hybrida ‘Apeldoorn’에서 오히려 독성피해를 주었다는 연구결과와 유사하였다(van Doorn et al., 1989, 1990). 생체중은 모든 처리구에서 증가하다가 절화수명 종료 시점이 시작된 처리 6일부터 점차 감소하였고, 수분흡수율은 점차 증가하는 경향을 나타냈다. 절화수명이 짧았던 ClO2 8μL・L-1와 8-HQS 200μL・L-1 처리구는 대조구보다 생체중과 수분흡수율이 낮았다(Fig. 1).
항균효과
식물체 유무에 따른 보존용액 내 ClO2의 잔존농도를 분석한 결과, 식물체가 없을 때보다 식물체가 있을 때 ClO2가 급격히 감소하였다. 특히 식물체가 있는 보존용액에서는 처리 후 2일 정도 잔존하는 것으로 확인되었다(Fig. 2). 이것은 Grevillea ‘Crimson Yul-lo’의 줄기를 Cl 40mg・L-1의 보존용액에 0, 1, 2, 4, 6개를 넣었을 때 줄기수가 증가할수록 Cl의 잔존농도가 급격하게 감소하였는데(Xie et al., 2008), 이것은 줄기 단면적이 증가함에 따라 ClO2의 소모가 빨라진 것이며, ClO2 농도가 높을수록 잔존일수가 늘어난 점도 이를 뒷받침해 본다. 장미의 절화수명 종료시점이 시작되는 처리 6일째 보존용액 내 세균수는 TW와 DW에서만 각각 3.7 × 105CFU・L-1와 6.3 × 105CFU・L-1로 검출되었고, ClO2와 8-HQS 처리구에서는 농도에 관계없이 전혀 검출되지 않았다(Table 2 and Fig. 3). 이것은 절화장미를 증류수에 두었을 때도 세균증식이 일어났다는 기존연구결과와 일치하였다(Kim et al., 1997; Lee and Kim, 2013). Macnish et al.(2008)는 Grevillea ‘Monarch’를 대상으로 ClO2 2와 5μL・L-1 보존용액처리 시 3일까지는 보존용액 내 세균축적을 억제시킬 수 있었으나, 3일 이후 항균효과가 없어지고 세균축적에 의한 꽃목굽음 현상이 일어났다고 보고하였다. 본 실험에서는 처리 6일째에도 ClO2의 항균효과는 지속되었다(Table 2 and Fig. 3). 절화장미의 도관폐쇄를 일으키는 세균은 Pseudomonas fluorescens, Aeromonas hydrophila, Klebsiella oxytoca이 있으며, 이들 특정 세균 1 × 105CFU・L-¹을 보존용액에 접종한 처리구에서 절화장미의 꽃목굽음율이 급격히 증가하였고(Kim et al., 1997), 특히 107-1011CFU・L-1의 박테리아가 검출되었을 때 도관막힘이 일어나 절화수명을 단축시키는 것으로 보고되었다(Macnish et al., 2008; van Doorn et al., 1989). 본 실험에서는 DW에서 6일째 박테리아가 검출되었으나 도관막힘이 일어날 정도의 박테리아 축적은 일어나지 않아 다른 처리간의 절화수명에 큰 차이를 보이지 않은 것으로 판단된다(Table 1 and 2). 본 실험에서 ClO2 4μL・L-1의 보존용액 처리와 200-250μL・L-1 침지처리(60s)에서 절화수명을 유의하게 연장시켰으며, ClO2 2-8μL・L-1 범위에서 식물체 독성증상이 없었다. 또한 ClO2는 농도에 따라 2-4일 정도 잔존하였다. 따라서 장미의 절화수명과 관련된 박테리아의 도관 축적은 수확 초기에 이루어지며 ClO2를 통해 이를 억제시킬 수 있다.